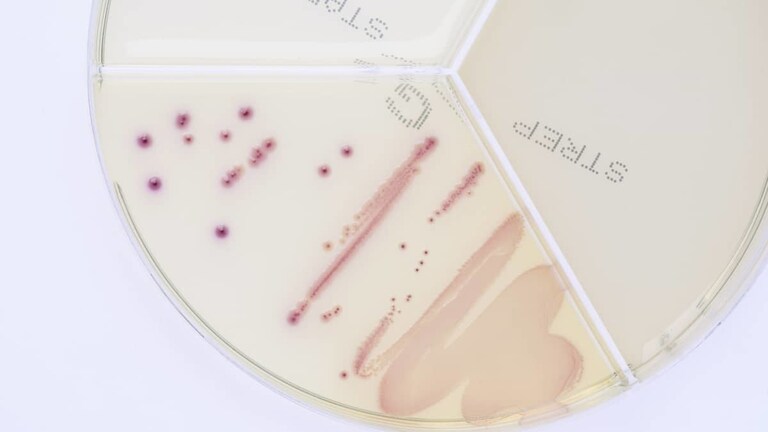

Zapalenie wymion wywołane przez bakterię Escherichia coli zwykle występuje jako ostra, czasem nawet nadostra (bardzo ciężka) choroba z ogólnym zaburzeniem stanu zdrowia. Gruczoł mlekowy jest powiększony, sztywny, ciepły i bardzo bolesny. Pozaustrojowe węzły chłonne są mocno powiększone i bolesne w dotyku. Krowa mleczna ma gorączkę, szybkie bicie serca, szybki oddech, przestaje jeść i żuć oraz może mieć zespół toksyczny, którego kulminacją jest zastój mleka, szok i śmierć.
Escherichia coli to bakteria, która w sprzyjającym środowisku, którym niewątpliwie są gruczoły mlekowe bardzo aktywnie się namnaża (podział bakterii nawet częściej niż co 20 minut), w gruczole mlekowym szybko rozwija się proces patologiczny . Już 4 godziny po zakażeniu reakcja zapalna jest w pełni rozwinięta , a po kolejnych 2 godzinach . pojawia się gorączka i ogólne objawy zaburzeń stanu zdrowia.
Escherichia coli występuje w dużych ilościach w przewodzie pokarmowym bydła, innych zwierząt i ludzi. Nie znaleziono jeszcze szczepów wykazujących większe powinowactwo do gruczołu mlekowego, więc możemy spodziewać się, że praktycznie każdy szczep bakterii jest w stanie przeniknąć do wymienia i wywołać zapalenie jelita grubego . Zapalenie wymion może poprzedzać biegunka, np. podczas nagłej zmiany karmienia, pogorszonych warunków zoohigienicznych, zaburzenia metabolicznych itp. Zapalenie wymion wywołane przez E. coli jest szczególnym zagrożoniem u krów mlecznych wysoko użytkowych i krów mlecznych, które mają zmniejszoną zdolność do zamykania strzyków kanału - E. coli może bardzo dobrze przylegać do splotu dzięki krótkim wypustkom wystającym z powierzchni komórki bakteryjnej (tzw. fimbrii), a następnie tworzyć biofilm i rozprzestrzeniać się w górę do wymienia. Co ciekawe - u człowieka w ten sposób dochodzi do infekcji pęcherza.
Do zakażenia wymion E. coli dochodzi najczęściej w ciągu trzech tygodni po wycieleniu, kiedy zwieracze strzyków nie pracują prawidłowo, a proces zamykania trwa do 30 minut, w porównaniu do 10 minut w późniejszych etapach laktacji.
Escherichia coli ma szereg podtypów różniących się stopniem agresji (produkcja toksyn, przenikanie do wymienia). Jeśli bakteria zostanie wypłukana podczas kolejnego doju, nie tworzy biofilmu i nie pozostaje w gruczole sutkowym, komórki somatyczne będą się powiększać tylko przez krótki czas (rzędu dni) w odpowiedzi na produkcję toksyn i wahania w przewodności mleka.
Inną możliwością jest tworzenie i reprodukcja biofilmu w wymieniu, produkcja toksyn, uszkodzenie nabłonka (wyściółki komórkowej), rozwój zapalenia jelit = reakcje zapalne, które nawet po skutecznym leczeniu trwają tygodniami.
W teście ClearMilk Escherichia coli rośnie w dużych, różowych koloniach. Bardzo dobrze rośnie w ciągu 24 godzin i należy jak najszybciej zbadać wrażliwość na antybiotyki – aby kontrolować rozpoczęte już leczenie , ponieważ E. coli jest jedną z bakterii, u których często występuje antybiotykooporność.
Na zdjęciu (powyżej) z badania mleka od krów mlecznych z zapaleniem wymion widzimy, że bakterie Escherichia coli i np. Streptococcus uberis można odróżnić kolorem i wzrostem w jednym z sektorów szalki, dzięki czemu w ciągu 24 godzin w gospodarstwie możemy mieć pierwsze informacje o patogenie zapalenia wymion.